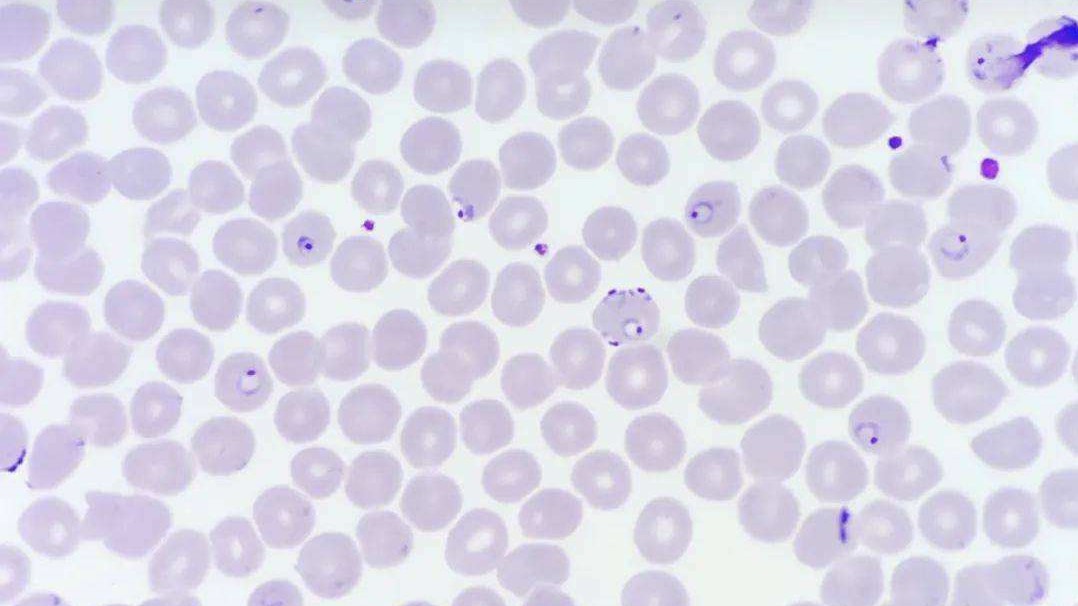
一瓶“甲硝唑”几块钱，或许能“摆平”4种病，不妨了解一下

张女士最近有点困扰,胃部感觉不舒服,有时候还会出现口臭的症状。为了弄清楚自己究竟是怎么了,赶紧去就近的医院进行就诊。
描述完症状之后,被问道“你们家里是不是其他人也会偶尔有这样的症状?”
“哎?你怎么知道的?”
“这个情况,八成是家里人感染了幽门螺杆菌。”
“先给您开一点甲硝唑试一下。”
“甲硝唑?幽门螺杆菌?没听说过啊。”
那么甲硝唑究竟是一种什么药物?都能应用于哪些方面?它真的可以解决幽门螺旋杆菌感染的问题吗?下面让我们来一一揭晓答案。

几块钱一瓶的甲硝唑,或许能“摆平”这4种疾病
甲硝唑又叫做“灭滴灵”,是硝基咪唑类药物的一种。因为其具有广谱抗厌氧菌和抗原虫的作用,甲硝唑在生活中被广泛使用。这种药物在维持较高的杀菌能力之下,还能保持较低的使用成本,很是不易。
甲硝唑之所以对厌氧菌和原虫会有很强的效果是因为其进入人体之后会被还原成硝基咪唑类化合物,抑制原虫和厌氧菌的还原反应,从而干扰厌氧菌和原虫的DNA合成。

甲硝唑剂型多种多样,能够通过多种方式给药,口服吸收迅速又完全,生物利用度能够达到95%以上。
而且这种药物吸收之后在人体内分布较广,相对于其他药物更容易进入组织和体液之中。更是由于其亲脂性的化学结构让这种药物能够有效穿过血脑屏障,使其能够在脑脊液中达到和维持所需要的治疗浓度。可能稍微美中不足的地方就是甲硝锉片剂的味道确实是太苦。

良药苦口利于病,甲硝唑虽然味道很苦,但却是对付原虫的一把好手。
就比如说阿米巴病,由溶组织内部的阿米巴原虫引起的寄生虫疾病。通常情况下,在人不经意间吃下受包囊体污染过的食物之后被感染。
侵入人体的包涵体一般在肠道定居,随着时间的推移,会出现滋养体和包囊体两种形式的阿米巴原虫。滋养体侵入结肠壁发育,会引起肠粘膜的坏死和溃疡等,对肠道造成严重的伤害。
被感染的患者会出现腹泻、腹胀和腹痛等症状,还有部分人群伴有体温升高等全身症状。

这些成长了的大滋养体不会满足于呆在这个小小的直肠,他们能够顺着感染者血液在身体里面四处流动不断入侵肝、肺、脑部等。继发性的阿米巴病还能引起脓肿、腹泻、恶心、呕吐、干扰患者正常的生理过程。
就是这样一个麻烦众多的疾病,却能被几块钱的小小一瓶甲硝唑轻松搞定。甲硝唑能够干扰大滋养体的DNA复制和已经合成的DNA正常发挥作用因此具有很强的灭杀作用。
作为治疗急性或者慢性阿米巴病的首选药物,对阿米巴痢疾和阿米巴肝脓肿的治愈率接近100%,真的就是属于便宜又好用的宝藏药物。
妇科疾病是很多女性的难题,阴道毛滴虫炎就是其中的一种,这种寄生虫同样也在甲硝唑的抗原虫图谱之中。
这种疾病基本都是通过*行为性**传播的,然而不注意个人卫生和使用某些不干净的公共设施(马桶,浴池,或者是公共游泳池等)也是潜在的传染源,实在是叫人防不甚防。
感染阴道毛滴虫的患者,很大程度上阴道的分泌物会出现异常,不仅有异味,分泌物的颜色也会发生改变。情况严重的话甚至影响正常排尿,出现尿频、尿急、血尿等症状。此外它还会引起瘙痒、疼痛等。

但是这种难缠的妇科疾病依旧难逃甲硝唑的作用范围,对于制造疾病的阴道毛滴虫,甲硝唑甚至能够依靠其干扰DNA复制的作用做到直接灭杀。
除了阴道毛滴虫炎,甲硝唑还可以作用在其他的滴虫性阴道炎上,对细菌性阴道炎依旧有奇效,能够快速高效灭杀造成阴道感染的厌氧菌。
不止是妇科疾病,甲硝唑同样对男性泌尿生殖道的滴虫感染也有效果。因为甲硝唑在抗原虫作用的同时兼具抗厌氧菌的作用。

阿米巴原虫,毛滴虫什么的或许平时没有听说过,但是幽门螺杆菌肯定是耳熟能详。它是最贴近我们生活的一种厌氧菌,能够导致消化不良,腹部的灼烧感,呕吐还有不可避免的口臭,这些症状都严重影响正常社交生活。
幽门螺杆菌感染对胃部的影响更大,感染严重者更有可能导致糜烂性胃炎,消化性溃疡出血等。而且幽门螺杆菌有一定的致癌概率。
幽门螺杆菌在我国的感染率大约是50%~60%之间,非常常见。可以通过唾液传播,比如说在饭桌上给家人,朋友夹了一筷子菜都有可能导致感染,传染效率高,而甲硝唑可以通过干扰DNA的复制来治疗这种难缠的厌氧菌。

很多人大概都会有口腔疾病的体验,“牙疼不是病,疼起来要人命”就是一部分口腔疾病的真实写照,虽说算是小病但是对日常生活的影响确是不输于前面几个。
牙疼的一部分原因是因为口腔内部厌氧菌感染。甲硝唑广泛的抗厌氧菌谱正好可以与之对应,牙龈肿痛,牙周脓肿,智齿都能够有效缓解。
但是一般情况,甲硝唑不做单独使用,也只是有效缓解并不能做到根治,暂时解决厌氧菌起到止疼的作用。

不只是这四种常见的疾病,甲硝唑同时还对呼吸道、消化道、盆腔、腹腔皮肤软组织、骨和骨关节的感染也具有一定的效果。就连脆弱拟杆菌导致的心内膜炎,败血症以及脑膜炎也同样在甲硝唑的作用范围之内。
即使甲硝唑是对付厌氧菌和原虫的有效药物,但是“是药三分毒”,需要服用甲硝唑时一定要谨遵医嘱,尤其是要多留意服药注意事项。

注意!服用甲硝唑时要注意这些方面
首先要做到的就是在服用甲硝唑期间和最后一次服药后,至少72小时内避免饮酒和含有酒精的产品。
一方面作为硝基咪唑类药物的甲硝唑和酒精会在人体之中和产生反应,抑制酒精代谢、同时干扰双硫仑代谢。另一方面由于制备方法的原因,甲硝唑之中很有可能含有甲硫四氮唑侧链,而这个基团也可以与酒精中的乙醇反应,发生双硫仑样反应。
双硫仑样反应有可能会导致痉挛、头晕、头痛、胃部不适、血压降低等不适症状。症状较轻的双硫仑样反应可以随着时间自行恢复,而如果情况比较严重的话可以引起呼吸抑制、虚脱、心功能失常等,甚至能够死亡。
所以说喝酒不吃药,吃药不喝酒,服药不规范,亲人两行泪。

即使不喝酒,甲硝唑也禁用于妊娠期间的妇女。因为它较强的亲脂性不仅可以通过血脑屏障也可以通过胎盘屏障从而影响婴儿的正常生长发育,有可能对婴儿的神经血管发育方面造成不可逆转的损坏,还有可能导致畸形的发生。
不只是妊娠期,哺乳期的妇女也是禁止使用的,甲硝唑可以在肝脏代谢之后经过乳汁排泄,对于身体发育的婴幼儿来说也能造成一定的影响。

甲硝唑由肝脏代谢,大部分代谢产物经过肾脏排泄出去,有一定的肝,肾负担。所以肝功能不全的人群应该根据自己的实际情况减少用量,避免带来过大的负担。
服用甲硝唑的时候应该控制饮食的咸淡,减少食盐的摄入,甲硝唑对肾脏有一定的负担,食用食盐过多导致钠元素摄取过多则有可能引起钠潴留,对身体造成一定的损害。
甲硝唑的注意事项就是这些,但是用药注意也避免不了一些副作用的发生,所以出现以下不良反应时,一定要及时停药。

甲硝唑的副作用都有哪些?
在甲硝唑服用期间,代谢产物会使尿液呈现深红色,面对这种情况不需要担心,这是正常现象。
甲硝唑副作用是少而轻的,没有什么太大的反应,主要以对胃肠道造成刺激引起的不良反应为主,有恶心,呕吐,食欲不振等情况。

还有少部分患者可能出现皮疹、红斑、以及白细胞减少的情况。
而白细胞减少又会带来头昏或者乏力等状况,由于白细胞也是免疫系统的一部分也还是有可能造成免疫力的降低。
由于甲硝唑较好的亲脂性能够通过血脑屏障,罕见有中枢神经中毒,比如说神经衰弱、头痛、运动失调、偶有感觉异常、肢体麻木、多发性神经炎等,遇到这种情况的出现就应该立刻停止用药。

结语
甲硝唑作为药物效果优良,价格低廉,非常亲民,但是它的归类还是属于处方药,还是要听从主治医生的医嘱才能进行服用。同时要注意使用事项,遇到出现不良反应的情况应该尽快就医,不要耽误的最佳的治疗时间。
参考文献:
【1】全国普通高等中医药院校药学类专业“十三五”规划教材,药理学(第二版)
【2】全国普通高等中医药院校药学类专业“十三五”规划教材,药物化学(第二版)
【3】甲硝唑栓及甲硝唑阴道泡腾片治疗阴道炎临床疗效对比观察 龚慧 官庄工区东兴医院 黑龙江中医药.2021,50(04)